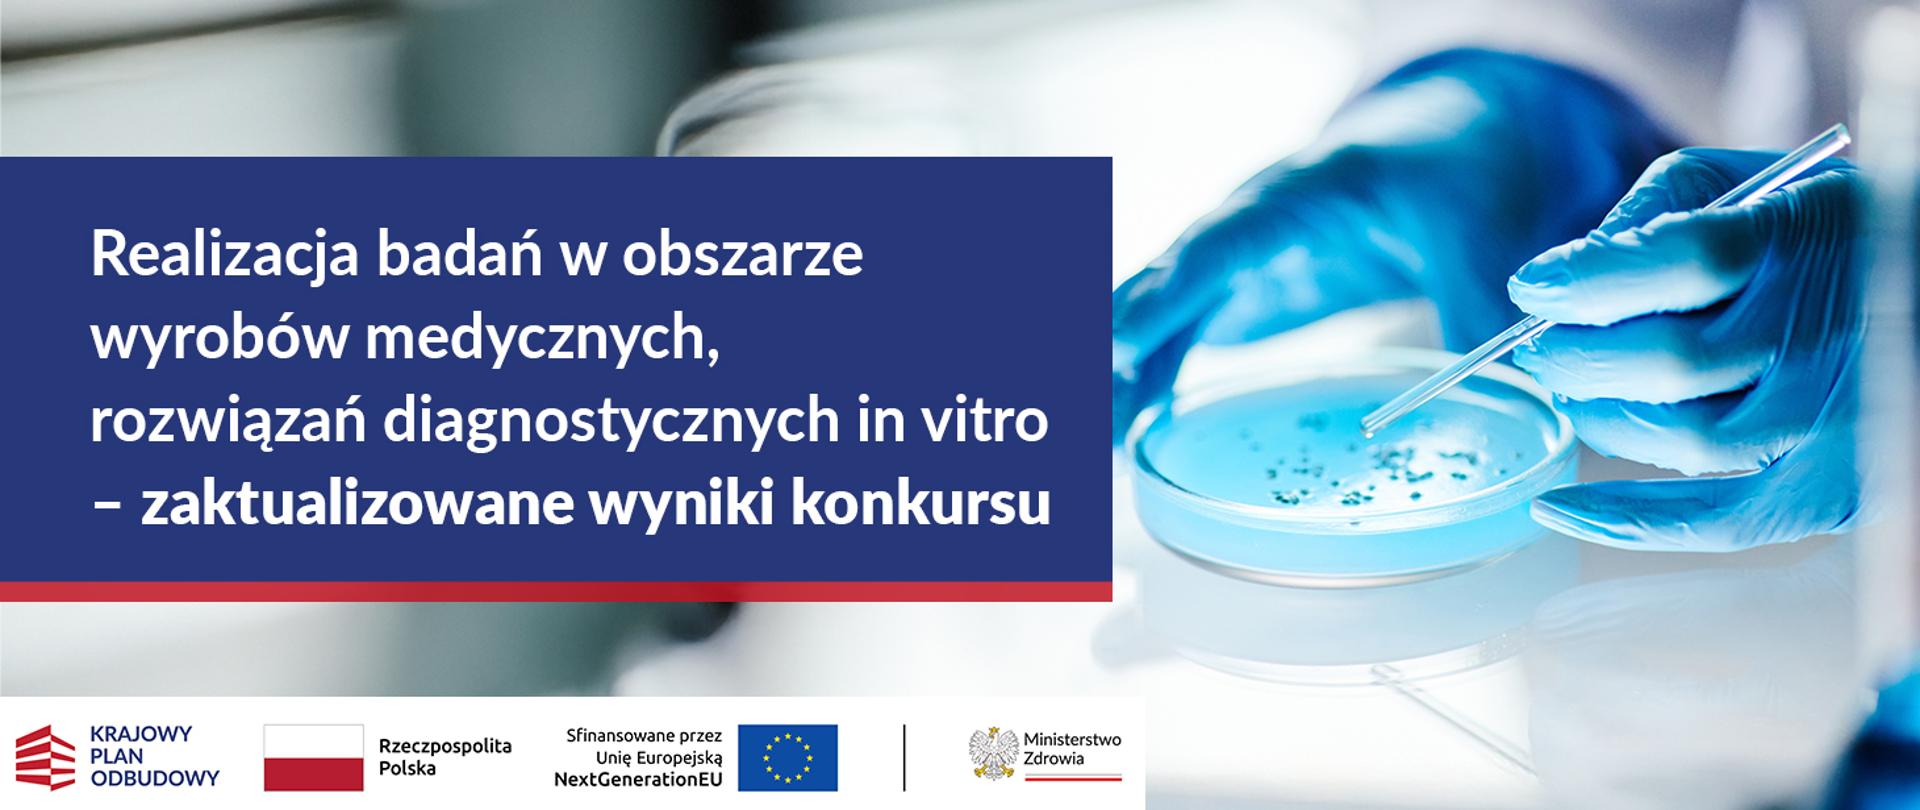
invitro-aktualizacja

Ogłoszenie listy rankingowej po uwzględnieniu procedury odwoławczej w Konkursie dla przedsiębiorców na realizację badań w obszarze wyrobów medycznych, rozwiązań diagnostycznych in vitro (2024/ABM/06/KPO)
14.04.2025
Prezes Agencji Badań Medycznych prof. dr hab. n. med. Wojciech Fendler zatwierdził listę rankingową zawierającą wyniki Konkursu dla przedsiębiorców na realizację badań w obszarze wyrobów medycznych, rozwiązań diagnostycznych in vitro (2024/ABM/06/KPO) w ramach Krajowego Planu Odbudowy i Zwiększania Odporności, która została zaktualizowana po zakończeniu procedury odwoławczej.
Na podstawie listy rankingowej sporządzonej w wyniku przeprowadzenia procedury konkursowej (w tym procedury odwoławczej) oraz dostępnej alokacji rekomendację do wsparcia w Konkursie otrzymało 10 projektów, dla których łączna kwota dofinansowania wynosi 36 896 230,76 zł.
Nabór wniosków trwał od 29 sierpnia 2024 r. do 28 października 2024 r. W ramach Konkursu wpłynęło 23 wnioski o łącznej kwocie wsparcia 94 478 395,88 zł. Do oceny merytorycznej zostało skierowanych 14 wniosków.
Lista rankingowa znajduje się poniżej.
Materiały
Lista rankingowa 2024/ABM/06/KPO po ponownej ocenie wnioskówLista_rankingowa_2024_ABM_06_KPO_po_ponownej_ocenie_wniosków_(1).pdf 0.19MB
